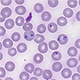

研究成果(プレスリリース)2015

2015年12月31日
113番元素の命名権獲得
2015年12月24日
植物の耐塩性を高める化合物を発見
2015年12月24日
歯の原基を操作して歯の数を増やす技術開発に成功
2015年12月24日
多様な臓器のがんで異常発現するRNA群を発見
2015年12月22日
テトラ中性子核を発見:中性子物質研究の本道を開拓
2015年12月21日
CD4陽性キラーT細胞への分化機構を解明
2015年12月18日
80年越しに見えてきた磁石・マグネタイト(Fe3O4)の本当の姿
2015年12月18日
分子が変形する様子を2兆分の1秒刻みでコマ撮り撮影
2015年12月18日
炎症反応を制御する新たな分子を発見
2015年12月18日
2つのシグナル物質の使い分けによる正反対の神経制御
2015年12月18日
肺の細胞が自ら歩いて集まる様子を撮影
2015年12月15日
上皮細胞が自律的に集団で移動する仕組みの発見
2015年12月10日
酸化タングステン光触媒の光キャリア超高速構造追跡に成功
2015年12月10日
新世界ザルのコモン・マーモセットで「ミラーニューロン」を世界で初めて発見
2015年12月9日
がんの全ゲノムシーケンス解析の新たなガイドラインを作成
2015年12月8日
50テスラ超強磁場まで維持される2次元超伝導状態を発見
2015年12月7日
マウス・ラットの肺炎病原体として新「科」微生物を命名
2015年12月2日
有機薄膜太陽電池で飛躍的なエネルギー変換効率の向上が可能に
2015年12月2日
がん細胞の運動を制御する新しい仕組みを発見
2015年12月1日
より高い超伝導臨界温度を実現する物質設計に新指針
2015年12月1日
強レーザーパルスを用いた量子状態の超高速高効率操作に成功
2015年11月30日
SACLAでタンパク質の硫黄原子を利用した結晶構造の決定に成功
2015年11月30日
Google Cloud Platformの活用により、レンダリング処理を200倍高速化
2015年11月27日
長期の乾燥による葉の黄化防止に関わる遺伝子を発見
2015年11月26日
不均一な生体試料を測定できる高性能NMR装置を開発
2015年11月24日
地球の液体外核の炭素量に制約
2015年11月24日
自然リンパ球によるアレルギー抑制機構を解明
2015年11月20日
物質と反物質の違いの理論的解明に道筋
2015年11月20日
新たな実験動物としてのソメワケササクレヤモリ
2015年11月20日
霊長類の大脳皮質で多細胞活動を長期間・同時計測
2015年11月20日
プリオン様タンパク質凝集体の抗ウイルス機能を発見
2015年11月16日
電気的に制御したグラフェンでバレー流の生成、検出に初めて成功
2015年11月13日
葉緑体が植物の成長を制御する新たな仕組みを発見

2015年11月12日
成長制御ホルモンが栄養依存的に産生される仕組みを解明
2015年11月12日
ポリケチド化合物の骨格形成に重要な酵素の機能解明

2015年11月10日
「京」にて現実大気の世界最大規模アンサンブルデータ同化に成功
2015年11月10日
細胞分裂のブレーキの働きを解明
2015年11月5日
近未来の照明のかたち:「さっと一吹き、できあがり」
2015年11月5日
細胞まるごと三次元画像データの自動解析法を開発
2015年11月4日
新たな代謝バイオマーカー探索法を開発
2015年11月4日
重いクロム・鉄同位体に広がる変形領域
2015年11月3日
哺乳類初期胚で新たな遺伝子発現制御の仕組みを解明
2015年10月30日
マラリア感染により腸内細菌叢が悪化する
2015年10月30日
アブシジン酸と拮抗的に働く新規化合物を同定
2015年10月30日
磁性絶縁体中の磁壁における金属的性質を観測
2015年10月29日
肝細胞がんで活性化するレトロウイルス由来のRNA
2015年10月27日
かび毒テヌアゾン酸の生合成遺伝子を同定
2015年10月26日
100℃以上の温度でのタンパク質の安定化機構を熱力学的に解明
2015年10月26日
薄膜積層化で整数量子ホール効果を従来より高温・弱磁場で実現
2015年10月23日
3次元時空の量子重力理論の厳密計算に成功
2015年10月23日
夢のスイッチが明らかにする夢を見る理由
2015年10月23日
多能造血前駆細胞を無限に増幅させる方法を開発
2015年10月22日
閉塞性動脈硬化症に関わる3つの遺伝子領域を発見
2015年10月20日
自発的なうつ状態を繰り返す初めてのモデルマウス
2015年10月15日
小児慢性疲労症候群患児の脳活動状態を明らかに
2015年10月14日
記憶や学習能力のベースラインは子ども時代につくられる!
2015年10月13日
磁気渦を押すだけで生成・消去できる新手法を発見
2015年10月13日
パルス電流によるスキルミオンの生成・消去に成功
2015年10月2日
"やる気や頑張り"がリハビリテーションによる運動機能回復に大切であることを脳科学的に証明
2015年10月1日
低電圧でも動作する有機強誘電体メモリーの印刷製造技術を開発
2015年9月30日
愛着障害児の報酬感受性の低下を解明
2015年9月30日
マウスの「父性の目覚め」に重要な脳部位を発見
2015年9月29日
らせん空孔が大面積で完全に配向した有機ゼオライト
2015年9月29日
社会的認知機能の巨大脳ネットワーク構造を解明
2015年9月26日
アト秒領域の超高速分子内電子状態を直接観測
2015年9月25日
電気で生きる微生物を初めて特定
2015年9月24日
炎症性腸疾患などに関与する免疫細胞の誘導メカニズムを解明
2015年9月24日
超高速光化学反応を可視化する「分子ムービー」の原理を実証
2015年9月24日
塗って作れる太陽電池の実用化に大きく前進
2015年9月24日
異なる環境を区別するオーシャンセルの発見
2015年9月23日
X線自由電子レーザーの可干渉性を可視化
2015年9月16日
パーキンソン病の新たな発症メカニズムをモデル動物で初めて解明
2015年9月15日
細胞内を移動するタンパク質「ダイニン」が 動いているときの構造が見えた!
2015年9月15日
生きた霊長類の脳内で神経細胞の「スパイン」を観察
2015年9月15日
アルツハイマー病の組織病変をズームイン
2015年9月14日
SACLAのX線自由電子レーザーを用いた新規タンパク質立体構造決定に世界で初めて成功
2015年9月1日
1,000兆分の1秒の時間遅延を観測
2015年9月1日
「ビフィズス菌BB536」による腸内細菌を介した生理機能の仕組みの一端を解明
2015年9月1日
自然免疫の記憶メカニズムを解明
2015年9月1日
神経細胞の形態の複雑さを決める新しい因子を発見
2015年8月28日
神経回路構築を制御する脂質を発見
2015年8月28日
植物の1細胞質量分析法プロトコールを公開
2015年8月27日
固体の結晶構造を記憶する液体:液体ビスマス中の奇妙な音波から証明
2015年8月27日
世界最短波長の原子準位レーザーを実現-金属銅箔から理想的なX線レーザー光が発生-
2015年8月26日
人工的に設計したタンパク質による金属ナノ結晶の生成
2015年8月22日
炭素のサッカーボールが集まるとなぜ高温超伝導体になるか
2015年8月21日
凍ったスピンをさらに冷やして量子効果で液体に融かす
2015年8月21日
凹みと平坦部を周期的に持った表面を機械的に形成
2015年8月17日
細胞内膜の裏側で、機能性脂質の動態の可視化に成功
2015年8月13日
日本近海の海面水温が関東の高温多湿な夏に寄与していることを発見
2015年8月13日
反陽子と陽子の質量を一千億分の一の超高精度で決定
2015年8月11日
内部の静電反発力のオンオフだけで動くヒドロゲル
2015年8月10日
革新材料・グラフェンの大量生産に大きな指針

2015年8月6日
コムギの塩ストレス耐性のメカニズムを解明
2015年8月5日
ニンニクの薬用成分を作る鍵となる遺伝子を発見
2015年8月3日
最新エクソーム濃縮キットの性能比較
2015年7月31日
赤外分光計測の飛躍的な感度向上に成功
2015年7月31日
超強力X線誘起電子分子ダイナミクスを解明!
2015年7月31日
短寿命の放射性同位体11CによるビタミンB1の標識に成功
2015年7月31日
膜孔形成毒素の作用を直接観察により解明
2015年7月31日
寄生植物の発芽誘導の仕組みを解明
2015年7月30日
水素の高速核スピン変換のメカニズムを実験的に立証
2015年7月30日
外的刺激で蛍光波長が可逆的に切り替わる有機蛍光色素を開発
2015年7月27日
ヒトの細胞間相互作用ネットワークの概要を可視化
2015年7月27日
身長や認知機能の個人差を生じる新しいメカニズムを発見
2015年7月24日
思春期特発性側彎症(AIS)発症に関連する遺伝子「BNC2」を発見
2015年7月21日
炎症性腸疾患の発症に関わる38カ所のゲノム領域を発見
2015年7月15日
マウスの難聴進行抑制に関与する遺伝子情報を網羅的に収集
2015年7月15日
ミナトカモジグサとコムギの蓄積代謝物の共通点と相違点を解明
2015年7月14日
固体中の異方的電荷分布を決定し可視化する世界初の研究手法を開発
2015年7月14日
スキルミオンの構造を制御する新原理を開拓
2015年7月10日
新原理で原子を操作
2015年7月7日
タンパク質の非常に速い構造変化を計測する新手法を開発
2015年7月7日
光による磁気弾性波の発生と磁区の駆動に成功
2015年7月6日
電子回路の「くびれ」に生じる微小な磁化を測定
2015年7月6日
シロアリ腸内の原生生物の表面共生細菌がリグノセルロース分解に寄与
2015年7月2日
室温以上でスキルミオンを生成する新物質を発見
2015年7月2日
QT延長症候群の原因遺伝子の候補を発見
2015年7月1日
世界最高磁場のNMR装置(1020MHz)の開発に成功
2015年7月1日
加齢による卵子の染色体数異常の原因を特定
2015年7月1日
固体中で非局所量子もつれを実証
2015年7月1日
概日時計が季節を読み取る仕組みを発見
2015年6月30日
植物の分化全能性抑制の分子メカニズムの一端を解明
2015年6月25日
重力によって移動方向が変わらないオーキシンを発見
2015年6月23日
細胞伸長の司令塔を配置する仕組みを解明
2015年6月18日
稲わら中の化成品原料成分の解明に成功
2015年6月18日
光遺伝学によってマウスのうつ状態を改善
2015年6月17日
超強力X線による極微小プラズマ生成を発見
2015年6月16日
細胞の分化状態の可視化に成功
2015年6月16日
新しい物質を実現するイリジウム酸化物の性質を解明
2015年6月11日
エリンギから眠り病の病原体の脂質を認識するタンパク質を発見
2015年6月8日
非対称な光学迷彩装置を理論的に実証
2015年6月5日
高秩序な大面積分子集積膜の構築に成功
2015年6月5日
コバルト酸化物に「悪魔の階段」を発見
2015年6月2日
バセドウ病の発症を予測するバイオマーカーを同定
2015年5月29日
記憶痕跡回路の中に記憶が蓄えられる
2015年5月29日
卵母細胞の分裂では微小管と染色体の接続が不安定
2015年5月27日
水銀・ストロンチウム光格子時計の高精度直接比較に成功
2015年5月26日
血圧上昇に関与する酵素を阻害する新規含硫黄代謝物を発見
2015年5月26日
新規アミノ酸を用いた酵素の安定化技術を開発
2015年5月26日
塗って作れる太陽電池で変換効率10%を達成
2015年5月25日
海洋天然物セオネラミドはコレステロールに結合し細胞膜の秩序を乱す
2015年5月22日
“感じる脳”のメカニズムを解明
2015年5月21日
腸管免疫システムにおけるレクチンの新たな機能を発見
2015年5月20日
マクロファージを活性化させる転写因子を発見
2015年5月18日
DNA情報の変換ルールを人為的に改変
2015年5月15日
有用プランクトンを細胞丸ごと計測する多次元固体NMR解析
2015年5月15日
デバイス内の熱による量子の流れに新理論
2015年5月14日
熱愛中にドーパミン神経が活性化する脳領域を解明
2015年5月12日
シロアリは腸内微生物によって高効率にエネルギーと栄養を獲得
2015年5月12日
重元素合成の鍵を握る中性子過剰核110個の寿命測定に成功
2015年5月8日
超並列分子動力学計算ソフトウェア「GENESIS」を開発
2015年5月8日
小胞体内腔タンパク質が血圧制御に重要な役割を果たす
2015年5月5日
生体内の低分子化合物を網羅的に捉える解析プログラムを開発
2015年4月28日
微生物が特定の形の代謝物を作るために必要な酵素遺伝子を発見
2015年4月28日
太陽光エネルギーを水素へ高効率に変換
2015年4月22日
哺乳類と爬虫類-鳥類は、独自に鼓膜を獲得
2015年4月22日
摘出臓器の生体外長期保存・機能蘇生技術を開発
2015年4月21日
高強度レーザーによるスペースデブリ除去技術
2015年4月21日
直観的な戦略決定を行う脳のメカニズムを解明
2015年4月15日
シャッター速度世界一の超解像蛍光顕微鏡を開発
2015年4月14日
トポロジカル絶縁体の表面ディラック状態の量子化を実証
2015年4月14日
多動障害や社会行動の異常を抑える新しい分子機構を発見
2015年4月13日
自然リンパ球の新しい発生メカニズム
2015年4月9日
糖・脂質代謝に重要なアディポネクチン受容体の立体構造を解明
2015年4月8日
海水を用いた淡水性ラン藻の培養に成功
2015年4月3日
新スーパーコンピュータシステム「HOKUSAI GreatWave」が稼働
2015年4月1日
ソルガムのデータベース「MOROKOSHI」をバージョンアップ
2015年3月31日
脂質の分布をありのままに観察する新技術
2015年3月27日
ヒト型多能性幹細胞の高効率樹立・安定維持技術を開発
2015年3月24日
酸化亜鉛界面を最高品質半導体レベルに向上させ、新たな量子相を観測
2015年3月24日
肉眼でも観察できる!従来の20倍光るタンパク質を開発
2015年3月24日
光通信デバイスに"透磁率"の概念を導入
2015年3月13日
細胞内巨大プロテインクリスタルの運命
2015年3月12日
形態形成などに関わるHhシグナル伝達系の分子機構の一端を解明
2015年3月11日
ncRNAの発現がiPS細胞とES細胞の違いを決める
2015年3月11日
星の「ストレス発散」で飛び散ったプラズマの拡散過程を観測
2015年3月9日
食品の非破壊放射能測定を実現する低コスト測定器の開発
2015年3月5日
セシウムと結合し植物への取り込みを抑制する化合物を発見
2015年2月23日
人と柔らかく接しながら力仕事を行なう高機能ロボット
2015年2月23日
微小で薄いタンパク質結晶の電子線構造解析
2015年2月19日
ヒトES細胞から毛様体縁を含む立体網膜を形成
2015年2月19日
原子同士が結合して新しい分子が生まれる瞬間をX線によってストロボ撮影
2015年2月18日
XFELを利用した計測の時間分解能を大幅に向上
2015年2月17日
ボツリヌス食中毒が起きる仕組みが明らかに!
2015年2月17日
筋肉を動かすカルシウムは筋肉を作る指令役も担う
2015年2月13日
地球深部の岩石中に中性水素原子が存在する可能性
2015年2月13日
高等植物の雄しべ発達過程を制御する植物ホルモン輸送体を発見
2015年2月13日
遺伝子制御部位の活性はエンハンサーが先行
2015年2月13日
光でオン・オフ可能な超伝導スイッチを開発
2015年2月10日
次世代時間標準「光格子時計」の高精度化に成功
2015年2月7日
タンパク質の「集合と拡散」による植物草丈制御の仕組みを発見
2015年2月6日
RNAポリメラーゼの働きを切り替えるメカニズムを解明
2015年2月6日
赤ちゃんに話かけるときは、はっきり発音していない
2015年2月6日
誰でも、どこでも、高分子を精密合成できる新手法を開発
2015年2月5日
均一な細胞集団に自発的に違いを生み出す仕組みを再構成
2015年1月30日
慢性肝炎や肝硬変は肝内胆管がんのゲノム異常と発生に強く関与
2015年1月30日
悪性リンパ腫の増殖を阻止できる可能性を見いだす
2015年1月30日
ヒトES細胞から小脳の神経組織への分化誘導に成功
2015年1月28日
生体試料の高分解能・高信頼度イメージング法を開発
2015年1月27日
内臓脂肪組織での制御性T細胞の増殖メカニズムを解明
2015年1月27日
単一サイクルX線パルスを発生するXFEL手法を考案
2015年1月20日
Ngly1タンパク質の欠損によりタンパク質分解反応に異常
2015年1月20日
コケ植物の光化学系Ⅰ複合体の集光アンテナ調節機構を解明
2015年1月16日
ボトルシップ型フェムト秒レーザー三次元加工技術を開発
2015年1月15日
アルツハイマー病を進行させる糖鎖を発見
2015年1月15日
植物ミトコンドリアへ選択的に遺伝子導入する手法を開発
2015年1月12日
ダイニン分子モーターの活性化機構の解明に向け大きく前進
2015年1月9日
細胞壁リグニンの分子構造を変える新しい方法を開発
2015年1月7日
脳損傷によって失われた運動機能を肩代わりする脳の変化を解明
2015年1月5日
植物のビタミンC輸送体を世界で初めて同定
